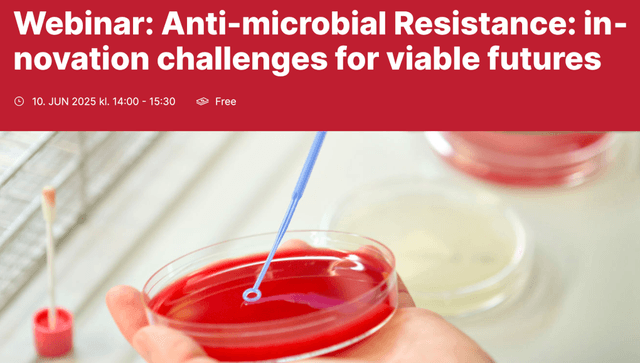

Antimicrobial resistance is not just a pressing global health crisis, but also a crisis of innovation
ALTERBIOTIC investigates current efforts to rebuild the antimicrobial innovation ecosystem by examining how key actors from science, industry, and policy imagine and pursue robust solutions to the AMR health and innovation crisis. Empirically, the project maps emerging alternative clinical, regulatory, and economic approaches to drive biomedical R&D in this field and analyses the complex political and technical ‘innovation challenges’ related to the timely, sustainable, and equitable development of new, effective antibacterial therapies.
About →We investigate the innovations that are currently pursued
ALTERBIOTIC develops a unique social science research approach to conceptualize the emerging antimicrobial innovation initiatives that were created in response to the AMR global crisis and the decline in antibiotic R&D. ALTERBIOTIC investigates in depth how these emerging initiatives and alliances aim to impinge on frameworks and regimes governing antimicrobial development, distribution and use – and whether and to which extent these challenge existing modes of innovation by creating alternative modes of innovation in the antimicrobial space.
Research →
Meet the ALTERBIOTIC team
Investigating the AMR innovation challenge requires multidisciplinary collaboration: Our social science team brings together researchers with diverse disciplinary backgrounds and areas of expertise, including Science and Technology Studies (STS), medical sociology, the history of medicine and public health, innovation policy studies, and medicinal chemistry. Together, we explore the emerging ‘alter-biotic’ innovation space through close collaboration in conceptual work, shared field-research activities, and individual subprojects.
Team →
All the Latest : News, Events, and More
Find out more here →
Christian Haddad presents work at EISAPEC-2025
27.08.2025
27.08.2025 ALTERBIOTIC PI Christian Haddad chaired a panel entitled ‘Shifting infrastructure of/for/in Global health: broken, emergent, reconfigured’ as part of the European International Studies Association Pan-European Conference (EISAPEC25) in Bologna, August 26-29, 2025. The panel investigated how infrastructures evolve, adapt, and transform in response to shifting global health challenges, and how these changes, in turn, […]

ALTERBIOTIC team members join MAE 2025 Conference
17.09.2025
17.09.2025 This year saw the Medical Anthropology Conference Europe arrive in Vienna – an opportunity not to be missed by the ALTERBIOTIC team. The conference brought together researchers from across Europe and beyond, to discuss how shifting definitions of health and wellbeing are shaping medical practices, policies, and everyday life. ALTERBIOITIC’s Kirstin Bentley joined the […]

GPSS Series on Antimicrobial Resistance: Innovation...
10.06.2025
10.06.2025 As part of the Global Pharmaceutical & Society Studies (GPSS) webinar series, Christian Haddad presented the ALTERBIOTIC project and its key research objectives, alongside a thorough conceptualization of the antibiotic innovation crisis. Social science research – and especially perspectives form Science & Technology Studies (STS) — are indispensable to grasp this crisis, as pharmaceutical […]